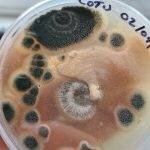
No-Pour Agar Tek | Mushroom Growing | Mushroom Blogs | Mushroom Growing | Mushroom Tips | Mushroom Business No-Pour Agar Tek | Mushroom Growing | Mushroom Blogs | Mushroom Growing | Mushroom Tips | Mushroom Business

There are dozens if not hundreds of different recipes for agar. These range from simple MEA through to Dogfood, Antibiotic, Water Bonemeal and even Blood agar. All have different applications for microbiology and a vast majority aren’t suitable for mushroom growing.
In April I received a 4-pack of free beer from the craft ale company Brewdog. This was a part of their marketing for the release of their new beer ‘Lost’ Planet first Lager. Great concept, not so great execution. The beer wasn’t great, especially when compared with some of their other varieties. However, it was free, so nothing lost.

These cans lay dormant in my fridge. Further down the line, as I was scientifically sampling some more beer, I started thinking about the components of beer. Water, Malt, Hops and Yeast. I concluded all these ingredients, excluding hops are used commonly in fungi agar work. A google search revealed that beer agar exists and is used to study the microorganisms in the brewing industry and so I was curious to see how mycelium would react. Not wanting to waste my good beer, I decanted the so-called ‘beer’ into a jug and microwaved it. I had a feeling that regardless of the species, mycelium wouldn’t do well on alcohol, the microwaving was my attempt to quickly boil it off, however, a saucepan would have been easier to control and probably more effective.

Next I added around 10g of Agar powder to the 500ml of so-called ‘beer’ and mixed with an emersion blender. I then sterilised the mixture at 121c for 15 minutes.

I let the liquid cool to around 45c and poured it into some petri dishes under sterile conditions. I inoculated the beer agar and regular MEA on the same day with the same species, Pleurotus Ostreatus, from the same plate with the same approximate size, volume and shape, using my handy-dandy agar transfer tool.


After incubating the plates at the same temperature (20c) for 7 days and the results were interesting.

As you can see the plate with the child’s handwriting marked ‘Beer’ is the Brewdog agar and the other one is simply MEA. The MEA plate has grown much quicker and bigger than the beer plate, however, the beer plates small growth looks much thicker than the MEA plate.


At this early stage I would be simply guessing as to the results and reasons. All the beer plates are the same level of growth as are the MEA plates. On paper this should work, I didn’t take an entirely scientific approach to this experiment, but I believe one factor holding back growth is the beer alcohol content. I believe I should have boiled the beer for longer and not in a microwave, however, I was scientifically sampling some other beer for science and the microwave was the logical choice.
Another possible thought is that the nutrient content is too rich for the mycelium. Further beer drin… Analysis is required. You can follow this experiment on my Instagram if you’re interested! Cheers for reading!



Antifungal effect of hops perhaps?
It could be, though it seems to be growing out quite nicely right now actually!
Check my IG for a more recent update!